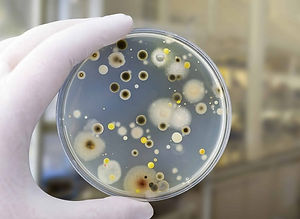
mold5.jpg

CALL US: 860.384.1941
EMAIL US: joel@qualityairct.com

OUR SERVICES
MOLD REMEDIATION
AIR QUALITY TESTING
At Quality Air, we offer comprehensive mold remediation services for both residential and commercial properties. Our team of experts uses the latest techniques and equipment to identify and remove mold from your property, ensuring that your indoor air quality is top-notch. We also provide air quality testing services to ensure that the air you breathe is safe and healthy.
MOLD INSPECTIONS

We specialize in long-term mold inspections for residential properties as well as for buying and selling of homes. Our team of certified professionals will conduct a thorough inspection of your property to identify any mold-related issues and provide you with a detailed report and a customized remediation plan.
EXPERIENCE

With over 11 years of experience in the indoor air quality field, you can trust Quality Air to provide you with the best possible service. We are committed to ensuring that your property is safe and healthy for you and your loved ones.